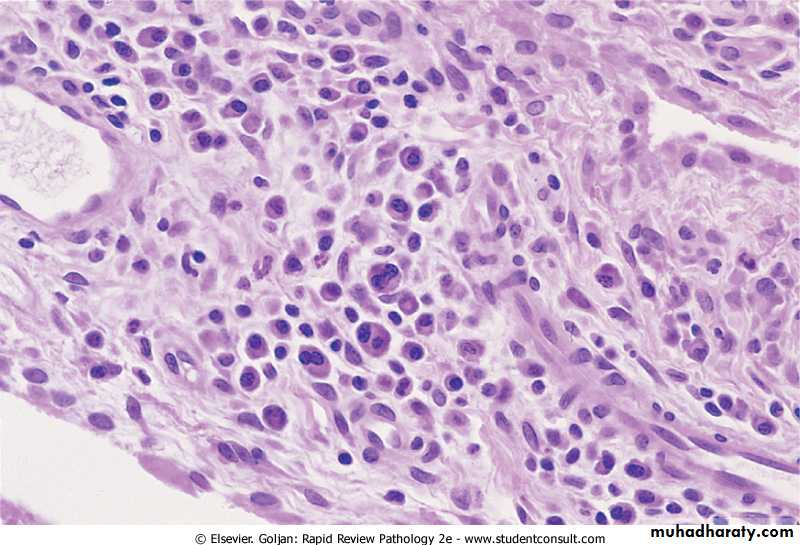

Chronic inflammation
Dr Mustafa Salah Fadhil MSc, FIBMS pathChronic Inflammation
Inflammation of long duration, characterized by:Predominance of lymphocytes, plasma cells & macrophages.
Productive (fibrous tissue) rather than exudative through formation of granulation tissue
ie: inflammation, tissue injury, and attempts at repair coexist together
Chronic InflammationMay arise in:
Progression from acute inflammationPersistent inflammation & suppuration (pneumonia--lung abscess)
Presence of indigestible endogenous (e.g dead bone), or exogenous (e.g suture)
Prolonged exposure to potentially toxic agents, either exogenous or endogenous eg: silicosis & atherosclerosis
Hypersensitivity diseases: excessive and inappropriate activation of the immune system
eg: autoimmune diseases: as in rheumatoid arthritis and multiple sclerosis.
allergic diseases: as in bronchial asthma
Primary chronic inflammation
Chronic inflammation
No initial phase of acute inflammatione.g.,
Certain infections e.g T.B, leprosy, brucellosis, viral
Specific diseases of unknown etiology e.g ulcerative colitis
Primary granulomatous diseases e.g sarcodosis
Chronic inflammation
Morphologic Features:Infiltration with mononuclear cells: including macrophages, lymphocytes, and plasma cells
Tissue destruction: induced by the persistent causative agent or by the inflammatory cells
Attempts at healing: by connective tissue replacement of damaged tissue, accomplished by angiogenesis and fibrosis
Cells and Mediators of Chronic Inflammation
1. Role of MacrophagesRepresent the dominant cells in most chronic inflammatory reactions
Secrete cytokines and growth factors
Initiate the process of tissue repair, scar formation and fibrosis.
Activating other cells, notably T lymphocytes.
Macrophages ingest and eliminate microbes and dead tissues.
Macrophage activation
Cells and Mediators of Chronic Inflammation
Role of Lymphocytes:Lymphocytes may be the dominant population in the chronic inflammation, autoimmune and other hypersensitivity diseases.
CD4+ T lymphocytes secrete cytokines, which promote inflammation and influence the nature of the inflammatory reaction.
Activated B lymphocytes and antibody-producing plasma cells are often present at sites of chronic inflammation.
Cells and Mediators of Chronic Inflammation
Role of Eosinophils:
Are abundant in immune reactions mediated by IgE and in parasitic infections
Recruited by specific chemokines (e.g., eotaxin) derived from leukocytes and epithelial cells.Produce major basic protein, a highly cationic protein that is toxic to parasites but also injures host epithelial cells.
Cells and Mediators of Chronic Inflammation
Role of neutrophils:Persistent microbes or by cytokines and other mediators produced by activated macrophages and T lymphocytes.
Osteomyelitis, a neutrophilic exudate can persist for many months.
Neutrophils also are important in the chronic damage induced in lungs by smoking
This pattern of inflammation has been called acute on chronic.
Morphology of Chronic Inflammation
Cell typesMonocytes and macrophages, lymphocytes and plasma cells, eosinophils
Necrosis
Not as prominent a feature as in acute inflammation
Destruction of parenchyma
Loss of functional tissue, with repair by fibrosis
Formation of granulation tissue
Chronic inflammation. This tissue shows an infiltrate of predominantly plasma cells (cells with eccentric nucleus and perinuclear clearing) and lymphocytes
Granulomatous inflammation
Special type of chronic inflammation in which the predominant cell type is an epitheloid macrophageEpitheloid macrophages: Activated macrophage that has acquired an enlarged, elongated epithelial cell-like appearance.
Macrophage giant cell: A large cell having numerous nuclei. 2 main types:
Foreign body GC
Langhan’s GC
Granuloma:
Granuloma:
An aggregate of epitheloid macrophages+/- surrounding rim of mononuclear infl cells
+/- surrounding rim of fibroblast & fibrosis+/- giant cells
+/- central necrosis e.g., caseating necrosis in TBCauses of granulomatous inflammation
Ways useful for final diagnosis causes of granuloma
Histological appearanceCertain technique e.g. special stain as AFB.
Serological tests as in syphilisPCR: Polymeraze Chain Reaction
Macroscopic appearance of chronic inflammation• Chronic ulcer
• Chronic abscess cavity• Induration & fibrosis
• Thickening of the wall of the hallow viscous
• Caseous necrosis